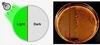

[IT동아 김영우 기자] 스타트업이 선보인 새 상품이나 서비스, 인사와 수상, 행사 참여와 간담회 개최 소식 등 최신 동정을 한 눈에 보기 쉽게 전해드립니다.
새롭게 출시된 플랫폼은 2025 대선 키워드를 기반으로 자동 설정되어 ▲대선 관련 언론 보도자료 ▲법안 발의 ▲의원 SNS 등 다양한 소스를 AI가 초 단위로 실시간 업데이트해 제공한다. 이를 통해 기업, 기관, 국회 및 정부 부처 담당자는 변화하는 정책 신호를 놓치지 않고 즉각 대응할 수 있다.
코딧, '2025 대통령 선거 정책 모니터링 플랫폼' 출시
AI 기반 법·정책 모니터링 플랫폼 기업 코딧(CODIT, 대표 정지은)이 4월 29일, '2025 대통령 선거 정책 모니터링 플랫폼'을 출시했다. 이번 서비스는 대통령 탄핵 인용 이후 조기 대선 체제 전환과 주요 정당의 후보 선출이 본격화되면서, 국내외 기업과 기관이 급변하는 정치·입법 환경에 선제적으로 대응할 수 있도록 지원하기 위해 마련됐다.코딧, '2025 대통령 선거 정책 모니터링 플랫폼' 출시 / 출처=코딧 |
새롭게 출시된 플랫폼은 2025 대선 키워드를 기반으로 자동 설정되어 ▲대선 관련 언론 보도자료 ▲법안 발의 ▲의원 SNS 등 다양한 소스를 AI가 초 단위로 실시간 업데이트해 제공한다. 이를 통해 기업, 기관, 국회 및 정부 부처 담당자는 변화하는 정책 신호를 놓치지 않고 즉각 대응할 수 있다.
특히 코딧은 대선 국면에서 정책 공백과 정치권 재편 등 복합적 리스크를 대비하는 것이 필수적이라고 강조했다. 지난 4일 발표한 ‘대통령 탄핵 인용과 향후 대선 전망’ 리포트에서는 짧은 대선 일정과 정책 불확실성 심화 가능성, 국내외 리스크 증가를 주요 변수로 제시하며, 지속적인 정책 모니터링이 필요하다고 제언한 바 있다.
정지은 코딧 대표는 “대선을 앞두고 각 당 공약은 물론 주요 정책, 법안, 뉴스 흐름을 면밀히 모니터링하고 변화에 신속히 대응하는 것이 어느 때보다 중요하다”며, “코딧은 AI 기술을 통해 기업과 기관이 필요한 정책 정보를 실시간으로 포착하고, 복잡한 정책 환경을 기민하게 대응할 수 있도록 돕겠다”라고 말했다.
해당 플랫폼은 코딧 공식 홈페이지를 통해 신청할 수 있으며, 대선 기간 동안 주요 정책 이슈에 대한 실시간 모니터링은 물론, 하루 최대 2회 맞춤형 알림 리포트와 필요 시 전문가 분석 인사이트도 제공한다. 또한, 대선 종료 후에는 별도의 절차 없이 신정부 정책 모니터링으로 자동 전환되어, 디지털, 공정거래, ESG 등 핵심 분야별 정책 변화를 지속적으로 파악할 수 있도록 지원할 계획이다.
KAIST GCC, 2025년 ‘초격차 스타트업 1000+ 프로젝트(DIPS)’ 로봇분야 킥오프 개최
한국과학기술원 글로벌기술사업화센터(센터장 최문기, 이하 KAIST GCC)는 ‘2025 초격차 스타트업 1000+ 프로젝트(DIPS) 로봇 분야 킥오프 미팅’을 4월 24일 온라인으로 개최했다고 전했다.로봇 분야 초격차 스타트업 신규 20개사 / 출처=KAIST GCC |
초격차 스타트업 1000+ 프로젝트는 초격차 10대 분야별 독보적인 기술 우위를 가진 스타트업을 발굴하고 글로벌 시장을 선도하는 기업으로 육성하는 사업이다. 로봇분야 기술사업화 주관기관으로는 KAIST가 2023년부터 참여하고 있으며 2025년 신규기업 20개사를 포함하여 총 77개사의 초격차 스타트업을 지원하고 있다.
이번 행사는 초격차 프로젝트 로봇분야의 총괄 책임을 맡고 있는 KAIST GCC 창업혁신성장실 권현정 실장의 2025년 지원 프로그램 소개를 시작으로 초격차 로봇분야 계속기업 57개사 소개와, ‘25년 신규기업 20개사 소개 순서로 진행되었다.
초격차 로봇분야 계속기업은 ▲엔젤로보틱스 ▲클로봇 ▲플로틱 ▲엑스와이지 ▲코가로보틱스 ▲마키나락스 등 산업용 로봇, 전문 서비스로봇, 개인 서비스로봇, 로봇 부품 및 소프트웨어, 시스템 임베디드 등 다양한 기술 분야의 기업들이 참여하고 있으며, KAIST는 이번 킥오프 미팅을 시작으로 기술 실증 및 사업화 지원 프로그램과 연계하여 국내외 시장 진입과 글로벌 확장을 본격화할 예정이다.
KAIST GCC측은 이번 행사와 관련, “초격차 로봇 분야 주관기관으로서 기술사업화, 글로벌 진출, 투자 유치 등에서 의미 있는 성과를 창출해 왔다”라며 “올해에도 글로벌 시장 진출 지원(유럽), 기술 아카데미, DIPS Tech Con 포럼, 로보월드 특별관 및 IR 피칭, USA Business Scale-up Program 등 다양한 프로그램을 통해 참여기업의 성장 발판을 마련할 계획”이라고 밝혔다.
세컨신드롬, 코스닥 상장 추진…주관사로 신한투자증권 선정
셀프스토리지 서비스 ‘미니창고 다락’ 운영사인 세컨신드롬(대표 홍우태)이 코스닥 진입에 도전한다. 세컨신드롬은 기업공개(IPO) 주관사로 신한투자증권을 선정했다고 4월 29일 밝혔다. 이번 IPO 추진은 국내 셀프스토리지 업계 최초 사례다.세컨신드롬의 ‘미니창고 다락' 이미지 / 출처=세컨신드롬 |
‘미니창고 다락(이하 ‘다락’)’은 주거지 인근에 위치한 도심형 공유창고로, 고객이 필요한 만큼의 공간을 원하는 기간 동안 구독 형태로 이용할 수 있는 셀프스토리지 서비스이다. 세컨신드롬은 AIoT(인공지능+사물인터넷) 기반 자동화 운영시스템으로 쾌적한 보관 환경을 조성하고, 전용 모바일 앱을 통해 편의성을 높였다.
세컨신드롬은 지난 2016년 다락을 처음 선보였으며 현재는 전국에 180여 개 다락 지점을 운영하고 있다. 특히 한국토지주택공사(LH)와 함께 더 이상 사람이 살지 않는 반지하주택을 다락으로 전환하는 사업을 적극적으로 추진하고 있다. 이러한 도시 활용의 혁신성을 인정받아 2024년 ‘도시지역혁신대상’에서 국토교통부장관상(대상)을 수상한 바 있다.
세컨신드롬은 지난해 매출 150억 원을 기록하며 전년 대비 25% 성장했다. 향후 고령화와 1인가구 증가 등 인구구조 변화 및 소득수준 향상으로 인한 셀프스토리지 수요는 한층 늘 것으로 기대된다. 또한, 세컨신드롬은 약 92조 원 규모의 글로벌 셀프스토리지 시장을 겨냥해, 고도화된 운영 솔루션의 해외 수출을 준비하고 있다는 소식도 전했다.
홍우태 세컨신드롬 대표는 “다락은 단순한 창고가 아닌, 사람들의 주거 생활을 윤택하게 바꾸는 플랫폼으로 지속적으로 성장해 나가고 있다”며 “코스닥 상장을 통해 세컨신드롬이 가진 기술력과 혁신성을 인정받고 더 큰 시장으로 나아갈 계획”이라고 밝혔다.
위플로, L2 에비에이션과 항공기 점검 기술 공동 개발 MOU 체결
미래 모빌리티 솔루션 기업 위플로(대표 김의정)가 글로벌 항공전자 통합 전문 기업 L2 에비에이션 솔루션즈(L2 Aviation Solutions, 이하 L2 에비에이션)와 항공기 점검 기술 공동 개발을 위한 양해각서(이하 MOU)를 체결하며 전략적 파트너십을 구축했다고 4월 29일 전했다.(왼쪽 부터)위플로 미국 사업 총괄 김승모 교수, 김영원 CTO와 L2 에비에이션 제프렉스(Jeff Rex) CRO, 토니 베일리(Tony Bailey) COO / 출처=위플로 |
위플로는 AI 및 데이터 기반 진단 기술을 통해 지상 및 항공 모빌리티 산업 전반의 안전성, 신뢰성 및 운영 효율성을 혁신하는 솔루션을 개발하는 기업이다. 지능형 멀티 모달 센서와 특화된 버티컬 AI 기술을 융합하여 드론, 에어택시, 전기차 등 다양한 모빌리티의 건전성 상태를 진단 및 예지하는 정비 솔루션을 제공한다.
L2 에비에이션 은 1997년 설립된 미국의 항공전자 통합 기업으로 최첨단 항공전자 솔루션과 전문성을 제공한다. EFI, FEAM AERO 등 글로벌 규모의 기업들에게 AOG(Aircraft On Ground) 지원, 인증, 엔지니어링, 장비 판매 등 광범위한 서비스를 제공한다.
이번 협약을 통해 위플로의 AI 기반 비접촉 진단 솔루션과 L2 에비에이션의 ▲항공 엔지니어링 ▲유지 보수 전문성 ▲인증 프로세스 및 운영 경험을 통합하는 데 협력할 예정이다.
김의정 위플로 대표는 "업계 선두에 위치한 L2 에비에이션과의 이번 MOU 체결은 위플로의 AI 기반 점검 기술이 글로벌 항공 시장에서 그 혁신성과 잠재력을 인정받는 중요한 계기가 될 것"이라며, "양사의 긴밀한 협력을 통해 항공 산업의 안전성과 효율성을 획기적으로 향상시키고, 향후 미래 항공 모빌리티(AAM) 산업으로 확장해 에어택시 기체의 자동 점검 솔루션을 개발하는 데 모든 역량을 집중하겠다"고 밝혔다.
토니 베일리 L2 에비에이션 COO(최고운영지도자)는 "첨단 AI 기술력을 보유한 위플로와의 전략적 협력을 통해 항공기 유지 보수 분야에 새로운 가능성을 열게 되어 매우 고무적이다"며, "양사의 축적된 경험과 전문성을 결합하여 더욱 안전하고 효율적인 항공기 운영 환경을 조성하고, 미래 항공 모빌리티 산업 발전에 적극적으로 기여할 수 있도록 노력하겠다"고 말했다.
인투코어테크놀로지, 기술성 평가 A·A 등급…코스닥 상장 본격화
플라즈마 기반 반도체 및 청정에너지 솔루션 전문기업 인투코어테크놀로지가 코스닥 기술특례상장을 위한 기술성 평가에서 A·A 등급을 획득했다고 4월 29일 밝혔다.인투코어테크놀로지, 기술성 평가 A·A 등급 획득 / 출처=인투코어테크놀로지 |
기술성 평가는 기술특례상장을 위한 필수단계로 신청 기업은 한국거래소가 지정한 두 곳의 전문 평가기관으로부터 기술성과 사업성을 평가받아야 한다. 인투코어테크놀로지는 두 기관으로부터 각각 A, A 등급을 받아 코스닥 상장예비심사 청구 요건을 달성했으며 이를 통해 코스닥 상장예비심사를 청구한다는 계획이다.
인투코어테크놀로지는 반도체와 청정에너지 분야에서 기술 경쟁력과 사업성을 인정받았다. 기술성 평가에서는 기술의 완성도와 경쟁우위도, 기술개발 환경 및 인프라, 제품 사업화 수준과 경쟁력, 시장 잠재력 등을 살핀다.
인투코어테크놀로지는 반도체 분야에서 반도체 제조 공정을 위한 RPS(Remote Plasma Source) 및 PPS(Plasma Pre-Treatment System) 장비를 개발·판매 중이다. 플라즈마 장비 기술력을 바탕으로 주요 글로벌 반도체 장비사들과 공동개발을 진행하고 있으며, 올해 차세대 리모트 플라즈마 공정 장비 출시를 예정하고 있다.
국내에서는 SK하이닉스, 삼성전자와 양산 평가를 활발히 진행하고 있으며, 주요 고객사 대상으로 제품을 판매 중이다. 또한 글로벌 진공펌프 업체와도 협력을 통해 PPS 장비 상용화를 추진하고 있다. 친환경 에너지 분야에서는 ▲수소나 SAF(지속가능항공유) 및 바이오 메탄올 등 청정 연료 ▲생산용 합성가스 ▲고급 탄소 소재 생산을 위한 플라즈마 기반 에너지 생산 장비 등을 개발하고 있다.
그 외에 수도권매립지관리공사와 탄소 네거티브 수소 생산 공동 연구개발 협약을 체결하고, 매립가스를 활용한 수소 생산 파일럿 플랜트 구축에 성공했다. 매립가스를 원료로 하는 SAF 생산 실증 플랜트 착공에도 돌입했다. 이 같은 성과를 바탕으로 인투코어테크놀로지는 삼성벤처투자, 산업은행, 지유투자 등 주요 기관 투자자들로부터 누적 투자를 유치한 바 있으며 중소벤처기업부가 선정한 '그린유망기업 100'에 이름을 올렸다.
엄세훈 인투코어테크놀로지 대표는 "어려운 시장 환경 속에서도 A·A 등급을 획득한 것은 당사의 반도체 및 청정 에너지 분야에서의 뛰어난 기술력과 사업화 가능성을 시장으로부터 인정받은 결과"라며 "앞으로도 전략적 파트너십을 강화하고 글로벌 시장에서 혁신을 이끌어 나가겠다"고 말했다.
알고랩, 2024년 매출 138억 원 달성
온디맨드 화물운송 스타트업 알고랩(대표 백승환)이 2024년에도 큰 성장세를 이어갔다고 4월 28일 전했다. 2024년 연간 매출은 전년 대비 약 71% 증가한 138.04억 원을 기록했고, 상각 전 영업이익(EBITDA)은 15.56억 원에 달했다.알고랩 2024년 실적 / 출처=알고랩 |
이로써 2019년부터 지난해까지 연평균 매출 성장률(CAGR)은 81.22%를 기록하였으며, 물류 스타트업 중 거의 유일하게 5년 연속 흑자를 냈다고 알고랩은 강조했다.
알고랩은 온디맨드 화물운송 서비스를 디지털 플랫폼을 통해 주선하는 기업이다. 온라인 퀵서비스 플랫폼 ‘알고퀵’과 바이크 탁송 모빌리티 ‘고바이크’를 운영하고 있으며, 현재 ▲네이버 ▲마켓컬리 ▲롯데칠성 ▲오스템임플란트 ▲무신사 ▲번개장터 ▲SPC그룹 ▲오늘의집 ▲신세계푸드 ▲한샘 등 다수의 대기업 및 스타트업에게 퀵서비스와 화물용달 서비스를 제공하고 있다.
알고랩은 2024년 한 해에 500개 이상의 신규 기업 고객을 유치하며 고객 기반을 대폭 확장했다. 올해 알고랩은 AI를 활용한 배차 최적화, 물류 자동화 솔루션 고도화, 고객사 맞춤형 인터페이스 개선 등에 집중해 시장 경쟁력을 더욱 강화할 예정이다. 또한 올해 매출 300억 원, 상각 전 영업이익(EBITDA) 40억 원을 달성하고, 내년에는 기업공개(IPO)를 추진할 계획이다.
팜스태프, 중국 중농이샹과 ‘스마트 식물공장 제조기지 구축’ MOU 체결
농산업 스마트솔루션 기업 팜스태프(대표 김정우)가 4월 22일 서울 JW메리어트호텔에서 개최된 ‘2025 청두(서울) 투자협력 설명회’ 에서 중국 도시농업 선도기업 중농이샹(四川中农亿享农业科技有限公司)과 ‘스마트 식물공장 지능장비 제조기지 구축’에 관한 MOU를 체결했다고 전했다.(왼쪽)김정우 팜스태프 김정우 대표와 (오른쪽)펑지에 중농이샹 총경리 / 출처=팜스태프 |
이번 설명회는 청두시 인민정부 주최로 열렸으며, 한중 양국 간 산업 협력과 투자를 확대하기 위한 자리로, 문화·관광·농업·첨단기술 등 다양한 분야의 유관 기관과 기업 관계자들이 참석했다.
팜스태프는 행사 마지막 순서인 프로젝트 협약 체결 세션에서 중농이샹과의 협약을 공식 발표하며, 한국의 스마트팜 기술을 기반으로 중국 내 제조기지 조성과 기술 협력을 본격화할 계획을 밝혔다.
이번 협약을 통해 양사는 ▲식물공장용 스마트 재배 장비 및 배지의 공동 개발 ▲현지 실증 및 양산체계 구축 ▲중국 시장 내 공동 브랜드화 전략 수립 등 실질적 실행이 가능한 협력 모델을 추진하게 된다.
김정우 팜스태프 대표는 “이번 MOU는 팜스태프가 보유한 실내 스마트팜 기술이 중국 시장과 맞닿는 첫 관문이자, 한중 간 농업 혁신 생태계를 만들어가는 실질적 발판”이라며 “각자의 강점을 살려 아시아 농업의 미래를 함께 열어나가길 기대한다”고 밝혔다.
한편, 팜스태프는 4월 25일, 강원도 화천의 협력 농장을 방문해 이번 협약과 연계된 양액배지 제품의 현장 적용성 및 공동 실증 가능성을 검토했다. 이를 통해 중국 시장에 적합한 기술 솔루션과 운영 모델을 더욱 구체화해 나갈 방침이다.
모빌린트, MXM 타입 AI 가속기 ‘MLA100 MXM’ 출시, 고성능 임베디드 시장 겨냥
AI 반도체 전문기업 모빌린트가 고성능 엣지 AI 시장 공략에 속도를 낸다. 모빌린트는 자사 AI 가속기 칩 ‘ARIES’를 기반으로 설계한 MXM(Mobile PCI Express Module) 타입의 AI 가속기 모듈 ‘MLA100 MXM’을 새롭게 출시했다고 4월 29일 밝혔다.모빌린트, MXM 타입 AI 가속기 ‘MLA100 MXM’ 출시 / 출처=모빌린트 |
MLA100 MXM은 25W의 저전력 환경에서 최대 80 TOPS(Tera Operations Per Second)의 연산 성능을 제공하며, 8개의 고성능 코어를 통해 복수의 AI 모델을 병렬 실행하거나 대규모 추론 연산을 안정적으로 소화할 수 있는 구조를 갖췄다.
또한, 82x70mm의 작은 크기와 110g의 가벼운 무게를 갖춘 MXM 규격을 채택했다. 이는 공간 활용성 및 전력 효율, 발열 관리가 중요한 ▲로보틱스 ▲산업 자동화 ▲엣지 서버 등의 임베디드 AI 시스템에 적합하다. 또한, MLA100 MXM은 LLM, VLM 등의 트랜스포머(Transformer) 모델 처리도 가능하다. 이를 통해 기존 GPU 기반 엣지 솔루션의 대안이 될 수 있다는 점을 모빌린트는 강조한다.
현재 국내 주요 엣지형 AI 솔루션을 보유한 대기업 및 산업 파트너들이 해당 제품을 기반으로 임베디드 시스템 통합 및 PoC(기술 검증 테스트) 협력을 착수하였으며, 이를 바탕으로 로보틱스, 스마트팩토리, 헬스케어 등 특화 시장에서 적용 범위를 확대해 나가고 있다고 모빌린트는 전했다.
모빌린트 신동주 대표는 “MLA100 MXM 카드는 로보틱스 및 엣지 디바이스에 서버급 추론 성능을 제공하는 것을 목표로 하고 있다”며, “AI 성능 극대화를 위해서는 하드웨어, 소프트웨어, 알고리즘의 균형이 핵심이며, 모빌린트는 자체 최적화된 소프트웨어 및 알고리즘 스택을 통해 이를 실현하고 있다”고 말했다.
IT동아 김영우 기자 (pengo@itdonga.com)
사용자 중심의 IT 저널 - IT동아 (it.donga.com)